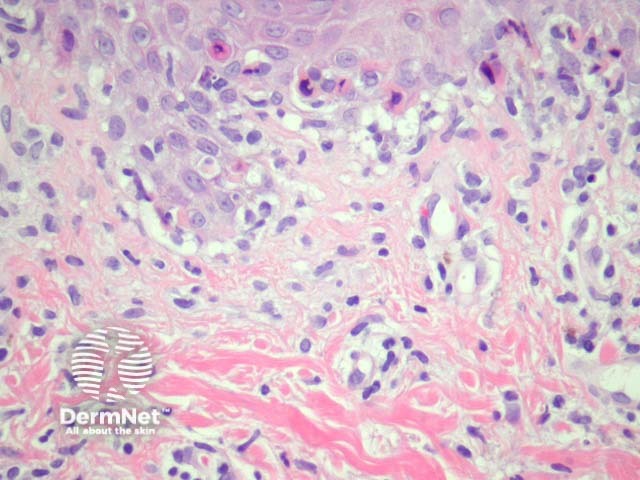
Figure 2

Main menu
Common skin conditions
NEWS
Join DermNet PRO
Read more
Quick links
Infections Diagnosis and testing
Author: Assoc Prof Patrick Emanuel, Dermatopathologist, Auckland, New Zealand, 2013.
Hand, foot and mouth disease is a viral illness caused by coxsackievirus A16 and enterovirus 71.
Hand, foot and mouth disease is rarely biopsied.
Sections usually show acral skin with a lymphocytic infiltrate which infiltrates the epidermis (figure 1). The infiltrate is associated with keratinocyte apoptosis in early lesions (figure 2). Figure 3 shows a high power view of a more established lesions: there is papillary dermal oedema (lower half of the field), epidermal necrosis, dyskeratosis, and intraepidermal vesiculation as a consequence of epidermal oedema.

Figure 1
Figure 2

Figure 3
PCR studies can be performed on tissue blocks for identification of coxsackievirus A16 and enterovirus 71.
Erythema multiforme – Early lesions of hand, foot and mouth disease can look very similar to erythema multiforme. Clinical correlation can be very helpful.